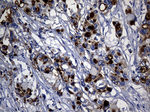
KRT14 Antibody in Immunohistochemistry (Paraffin) (IHC (P))

Search
OriGene
KRT14 Monoclonal Antibody (OTI5F2), TrueMAB™
{{$productOrderCtrl.translations['antibody.pdp.commerceCard.promotion.promotions']}}
{{$productOrderCtrl.translations['antibody.pdp.commerceCard.promotion.viewpromo']}}
{{$productOrderCtrl.translations['antibody.pdp.commerceCard.promotion.promocode']}}: {{promo.promoCode}} {{promo.promoTitle}} {{promo.promoDescription}}. {{$productOrderCtrl.translations['antibody.pdp.commerceCard.promotion.learnmore']}}
产品信息
TA803190
种属反应
宿主/亚型
分类
类型
克隆号
抗原
偶联物
形式
浓度
规格
纯化类型
保存液
内含物
保存条件
运输条件
靶标信息
Cytokeratins (CK) are intermediate filaments of epithelial cells, both in keratinizing tissue (ie. skin) and non-keratinizing cells (ie. mesothelial cells). At least 20 different CKs can be identified. Biochemically, most members of the CK family fall into one of two classes, type I (acidic polypeptides) and type II (basic polypeptides). Belonging to the type I subfamily of low molecular weight keratins and existing in combination with keratin 5, keratin 14 distinguishes stratified epithelial cells from simple epithelial cells and is useful in identification of squamous cell carcinomas. It is considered a prognostic marker in breast carcinomas. At least one member of the acidic family and one member of the basic family is expressed in all epithelial cells.
仅用于科研。不用于诊断过程。未经明确授权不得转售。
生物信息学
蛋白别名: CK-14; cytokeratin 14; Cytokeratin-14; K14; keratin 14, type I; Keratin, type I cytoskeletal 14; Keratin-14; Koebner
基因别名: CK14; EBS1; EBS1A; EBS1B; EBS1C; EBS1D; EBS3; EBS4; K14; KRT14; NFJ
UniProt ID: (Human) P02533
Entrez Gene ID: (Human) 3861